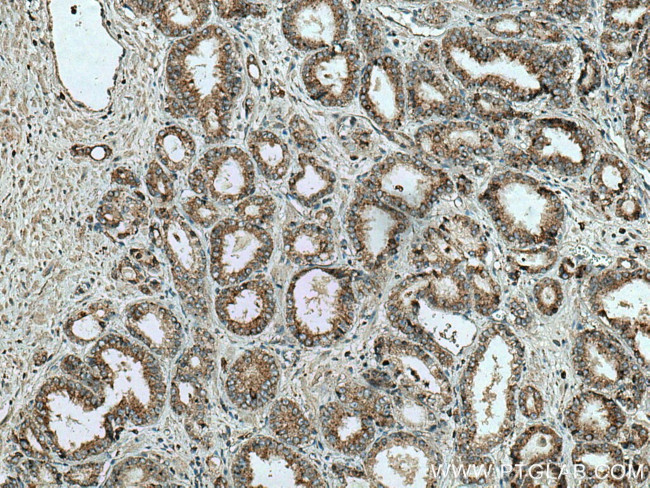
Prostein Antibody in Immunohistochemistry (Paraffin) (IHC (P))
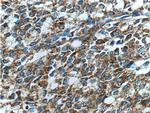
Prostein Antibody in Immunohistochemistry (Paraffin) (IHC (P))

Search
Proteintech
Prostein Monoclonal Antibody (5E12E2)
{{$productOrderCtrl.translations['antibody.pdp.commerceCard.promotion.promotions']}}
{{$productOrderCtrl.translations['antibody.pdp.commerceCard.promotion.viewpromo']}}
{{$productOrderCtrl.translations['antibody.pdp.commerceCard.promotion.promocode']}}: {{promo.promoCode}} {{promo.promoTitle}} {{promo.promoDescription}}. {{$productOrderCtrl.translations['antibody.pdp.commerceCard.promotion.learnmore']}}
产品信息
60343-1-IG
种属反应
宿主/亚型
分类
类型
克隆号
抗原
偶联物
形式
浓度
规格
纯化类型
保存液
内含物
保存条件
运输条件
产品详细信息
Immunogen sequence: REKQVFLPK YRGDTGGASS EDSLMTSFLP GPKPGAPFPN GHVGAGGSGL LPPPPALCGA SACDVSVRVV VGEPTEARVV PGRGICLDLA ILDSAFLLSQ VAPSLFMGSI VQLSQSVTAY MVSAAGLGLV AIYFATQVVF DKSDLAKYSA (405-553 aa encoded by BC050416)
靶标信息
Prostein is a novel prostate-specific protein expressed in normal and malignant prostate tissues. This protein appears to be a type IIIa plasma membrane protein with a cleavable signal peptide and 11 transmembrane-spanning regions. Prostein expression is androgen responsive since treatment of LNCaP cells with androgen up-regulates prostein message and protein expression levels. Thus, prostein is a prostate-specific marker whose detection and quantitation may be useful in diagnosing and monitoring prostate cancer.
仅用于科研。不用于诊断过程。未经明确授权不得转售。
篇参考文献 (0)
生物信息学
蛋白别名: prostate cancer associated protein 2; prostate cancer associated protein 6; prostate cancer associated protein 8; prostate cancer-associated gene 2; prostate cancer-associated gene 6; prostate cancer-associated gene 8; Prostate cancer-associated protein 6; Prostein; Solute carrier family 45 member 3; unnamed protein product
基因别名: IPCA-2; IPCA-6; IPCA-8; IPCA6; PCANAP2; PCANAP6; PCANAP8; PRST; SLC45A3
UniProt ID: (Human) Q96JT2
Entrez Gene ID: (Human) 85414